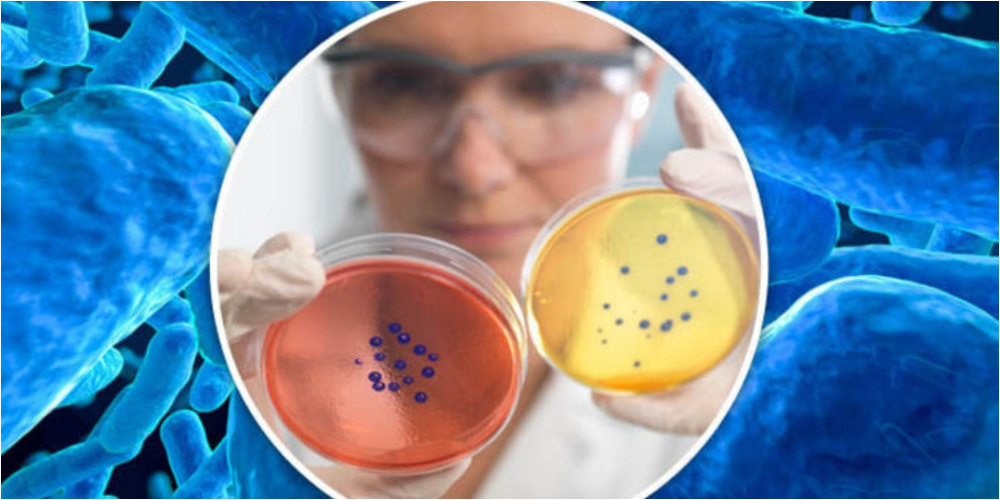

Назвали одну из самых опасных инфекций XXI века
Всемирная организация здравоохранения (ВОЗ) предупредила, что гонорея, одна из самых распространенных в мире инфекций, передающихся половым путем, все чаще демонстрирует устойчивость к антибиотикам. Новые данные глобальной программы EGASP показывают, что привычные методы лечения теряют эффективность, а инфекция распространяется быстрее и все шире.
Сообщается, что между 2022 и 2024 годами устойчивость к ключевым препаратам лечения гонореи - цефтриаксону и цефиксиму - выросла в несколько раз. Если раньше речь шла о единичных случаях, то теперь показатели достигли 5% и 11% соответственно.
ВОЗ подчеркивает, что расширение в последние годы числа стран, участвующих в программе EGASP, - позитивный шаг. Эта международная инициатива, запущенная ВОЗ в 2015 году, собирает лабораторные и клинические данные из контрольных центров по всему миру для глобального анализа и разработки рекомендаций по лечению.
В 2024 году свои национальные данные предоставили уже 12 государств, включая Бразилию, Индию, Южную Африку и Швецию. В этих странах было зарегистрировано более 3,5 тыс. случаев заражения гонореей, причем половина из них пришлась на страны Западно-Тихоокеанского региона.
Что нужно помнить, используя антибиотики.
"Средний возраст пациентов составил 27 лет, но диапазон варьировался от подростков до пожилых людей. Каждый пятый случай был связан с мужчинами, имеющими секс с мужчинами, а почти половина пациентов сообщили о множественных сексуальных партнерах за последний месяц. Дополнительные факторы риска - недавний прием антибиотиков и поездки за границу", - говорится в сообщении организации.
ВОЗ предупреждает: если устойчивость к антибиотикам продолжит расти, мир может столкнуться с ситуацией, когда привычные методы лечения перестанут работать.
"Это сделает гонорею одной из самых опасных инфекций XXI века", - предупреждают специалисты.
Организация призывает страны усиливать наблюдение, развивать диагностику и обеспечивать доступ к новым методам терапии, чтобы остановить распространение болезни.
Фото на главной странице иллюстративное: dzen.ru/a/ZeVrGbMsSQc7oUOz.